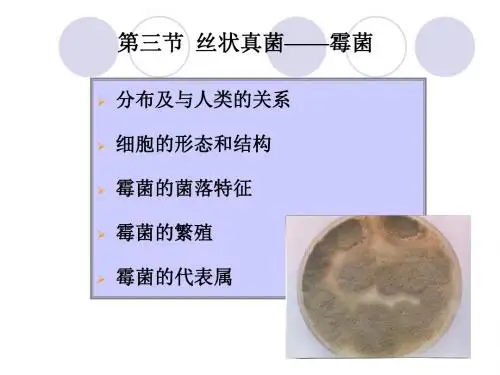

菌丝片段
有性孢子
无性孢子
合,只是由营养细胞分裂或分
化而形成同种新个体的过程。 霉菌的无性繁殖主要 通过产生以下四种类型的无性 孢子来实现。
担孢子 后垣孢子 卵孢子 接合孢子 子囊孢子 孢囊孢子 分生孢子 节孢子
1、孢囊孢子
由于生于孢子囊内,又叫内生孢子。
它是由气生菌丝顶端膨大形成特殊 囊状结构—孢子囊,孢子囊逐渐长大, 在囊中形成许多核,每一个核外包以原 生质并产生细胞壁,形成孢囊孢子。带
营养菌丝(基内菌丝):伸入到培养基内部,
以吸收养分为主的菌丝。 气生菌丝:向空中生长的菌丝。气生菌丝 发育到一定阶段可分化成繁殖菌丝。
营养菌丝的特异化
①假根:是根霉属(Rhizopus)真菌的匍匐枝与基质接触处
分化形成的根状菌丝,它起固着和吸收营养的作用。 ②匍匐菌丝:毛霉目真菌在固体基质上常形成与表面平行、 具有延伸功能的菌丝,称匍匐菌丝 ③吸器:是某些寄生性真菌侵入寄主细胞内形成指状、球状 或丛枝状结构,用以吸收寄主细胞中的养料。 ④子实体:是由真菌的营养菌丝和生殖菌丝缠结而成的具有
由 细 胞 壁 、 细 胞 膜 、 细 胞 质 、 细 胞 核 、 线 粒
细胞壁:除少数低等水生霉菌细胞壁含纤维素外,大部分霉 菌细胞壁主要由几丁质组成。 几丁质是由数百个N-乙酰葡萄糖胺分子以β-1,4糖苷键连 接而成的。几丁质和纤维素分别构成高等和低等霉菌细胞壁 的网状结构—微纤丝。微纤丝使细胞壁具有坚韧的机械性能。 组成真菌细胞壁的另一类成分为无定型物质,主要是一
在当前已知道的约5万种真菌中,被国际确认的人、畜致病
菌或条件致病菌已有200余种(包括酵母菌在内)。 引起食物中毒:霉菌能产生多种毒素,目前已知有100种以 上。例如:黄曲霉毒素,毒性极强,可引起食物中毒及癌 症。